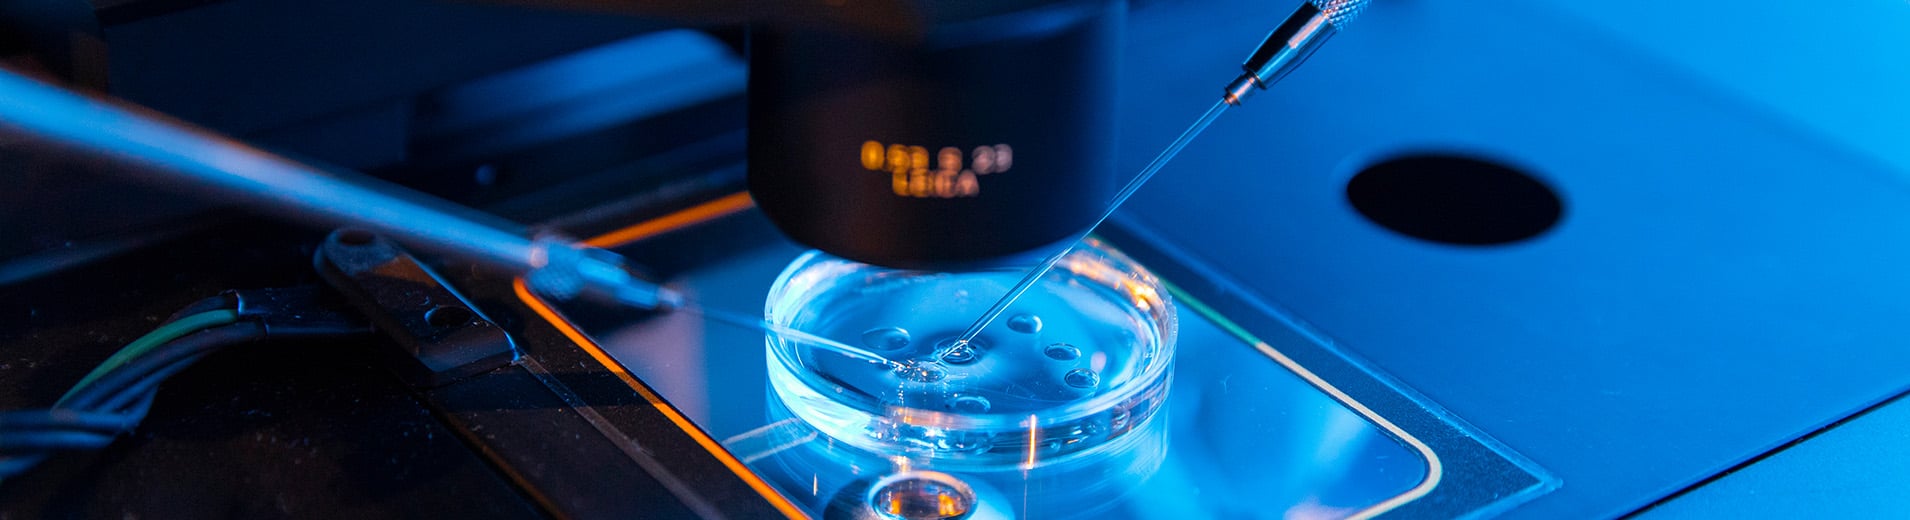

Giorgia Romitelli
PartnerLanguages
- Italian
- English
Awards
Education
- Law degree, University of Bologna.
Prior Experience
2007 - to date DLA Piper - Partner
2003 - 2006 DLA Piper - Associate
2001- 2003 Coudert Brothers, Milan - Associate
1998 - 2001 Studio Legale Prof. Guido Greco - Associate
Jan. 1998 - Nov. 1998 Studio Legale Prof. Giuseppe Pericu - Trainee
1995 – 1997 Avvocatura Distrettuale dello Stato - Trainee
Memberships And Affiliations
- Admitted to represent clients before the Supreme Court